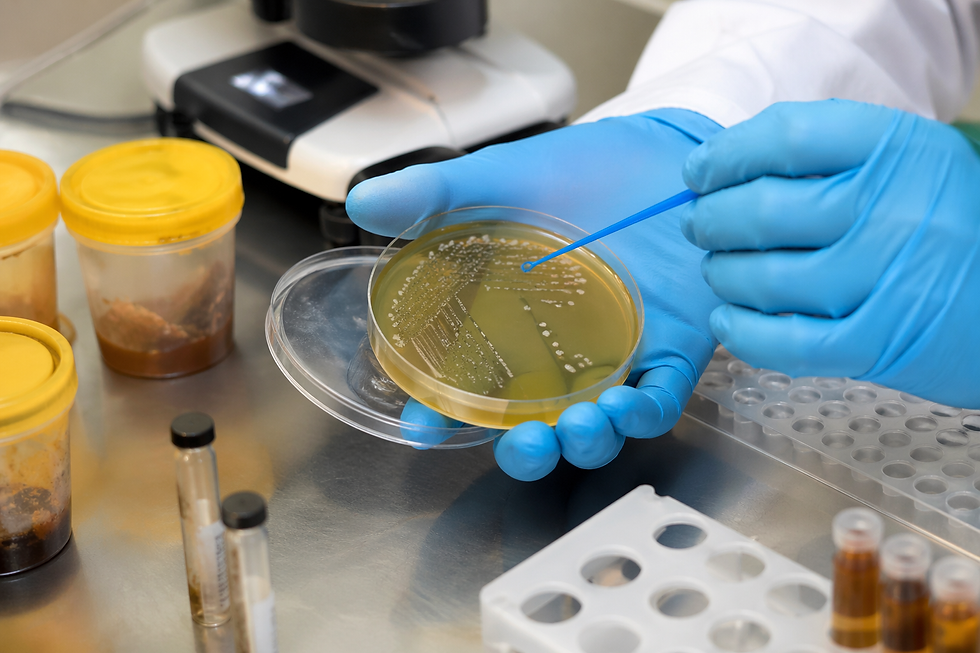

Métodos Laboratoriais para Detecção de Paenibacillus larvae: Avanços, Desafios e Aplicações no Controle Sanitário Apícola
- Keller Dantara
- 4 de abr.
- 8 min de leitura
Introdução
A sanidade apícola tem se consolidado como um dos pilares estratégicos para a sustentabilidade da produção de mel e derivados, especialmente diante da crescente demanda global por alimentos de origem natural e pela relevância das abelhas na polinização de culturas agrícolas. Nesse contexto, a bactéria Paenibacillus larvae, agente etiológico da Loque Americana (American Foulbrood – AFB), representa uma das ameaças mais severas à apicultura mundial. Trata-se de um microrganismo formador de esporos altamente resistentes, capaz de persistir por décadas em ambientes contaminados, tornando o controle da doença particularmente complexo.
A detecção laboratorial de P. larvae não se limita ao diagnóstico clínico da doença em colmeias afetadas. Ela desempenha um papel central na vigilância sanitária, na certificação de produtos apícolas, na prevenção de surtos e no cumprimento de exigências regulatórias nacionais e internacionais. Métodos sensíveis e específicos são essenciais para identificar a presença do patógeno em estágios iniciais, muitas vezes antes do aparecimento de sinais visíveis, o que permite intervenções mais eficazes e menos disruptivas para a cadeia produtiva.
Nas últimas décadas, o avanço das técnicas laboratoriais trouxe uma diversificação significativa de abordagens para a detecção de P. larvae. Métodos clássicos baseados em cultura microbiológica foram complementados — e, em alguns casos, parcialmente substituídos — por técnicas moleculares, imunológicas e bioquímicas de alta precisão. Esse desenvolvimento acompanha não apenas a evolução da microbiologia aplicada, mas também a necessidade crescente de respostas rápidas, confiáveis e padronizadas.
Este artigo tem como objetivo apresentar uma análise aprofundada dos métodos laboratoriais utilizados na detecção de Paenibacillus larvae, explorando seu contexto histórico, fundamentos teóricos, importância científica e aplicações práticas. Serão discutidas as principais metodologias analíticas, suas vantagens e limitações, bem como as tendências emergentes que podem redefinir o diagnóstico da Loque Americana nos próximos anos. Ao longo do texto, serão incorporadas referências a normas técnicas, estudos científicos e práticas institucionais consolidadas, oferecendo uma visão abrangente e atualizada sobre o tema.
Contexto Histórico e Fundamentos Teóricos
A Loque Americana foi descrita pela primeira vez no século XIX, sendo inicialmente associada a um processo de decomposição larval de origem desconhecida. Somente no início do século XX, com os avanços da microbiologia, foi possível identificar o agente etiológico da doença, então denominado Bacillus larvae, posteriormente reclassificado como Paenibacillus larvae com base em análises filogenéticas e bioquímicas.
O principal fator de virulência de P. larvae reside na sua capacidade de formar esporos altamente resistentes a condições ambientais adversas, incluindo variações extremas de temperatura, desinfetantes químicos e radiação. Esses esporos são ingeridos pelas larvas de abelhas, germinam no intestino médio e proliferam rapidamente, levando à morte do hospedeiro. A decomposição da larva gera milhões de novos esporos, perpetuando o ciclo de infecção dentro da colmeia.
Do ponto de vista microbiológico, P. larvae é uma bactéria Gram-positiva, anaeróbia facultativa, com crescimento relativamente lento em meios de cultura. A identificação tradicional baseia-se em características morfológicas, bioquímicas e fisiológicas, incluindo a formação de colônias irregulares e a produção de enzimas específicas. No entanto, essas características podem variar entre cepas, o que dificulta a padronização dos métodos convencionais.
A partir da década de 1990, o avanço das técnicas de biologia molecular permitiu a caracterização genética mais precisa de P. larvae, incluindo a identificação de diferentes genótipos (ERIC I a ERIC V), com variações significativas em virulência e comportamento epidemiológico. Essa diversidade genética reforça a necessidade de métodos diagnósticos capazes de diferenciar cepas e detectar o patógeno com alta sensibilidade.
No campo regulatório, diversos países estabeleceram normas para o controle da Loque Americana. No Brasil, o Ministério da Agricultura e Pecuária (MAPA) define diretrizes para o monitoramento de doenças apícolas, incluindo a obrigatoriedade de notificação de focos de AFB. Internacionalmente, a Organização Mundial de Saúde Animal (WOAH, anteriormente OIE) reconhece a doença como de notificação obrigatória, recomendando métodos laboratoriais validados para sua detecção.
Normas técnicas como as da ISO (International Organization for Standardization) e da AOAC (Association of Official Analytical Collaboration) também influenciam a padronização de métodos microbiológicos e moleculares aplicáveis à detecção de patógenos em alimentos e produtos de origem animal. Embora não existam normas específicas exclusivamente dedicadas a P. larvae em todos os casos, muitos protocolos adaptam diretrizes gerais para microrganismos esporulados.
Importância Científica e Aplicações Práticas
A relevância científica da detecção de Paenibacillus larvae transcende o diagnóstico clínico da Loque Americana. Trata-se de um elemento central na gestão sanitária da apicultura, com implicações diretas na segurança alimentar, na economia agrícola e na conservação ambiental.
Estudos indicam que surtos de Loque Americana podem levar à perda de até 100% das colmeias afetadas, especialmente quando não detectados precocemente. Em países com produção intensiva de mel, como Estados Unidos, Argentina e China, o impacto econômico pode atingir milhões de dólares anuais. Além disso, a necessidade de destruição de colmeias contaminadas — prática recomendada para evitar a disseminação do patógeno — representa um custo significativo para os apicultores.
Do ponto de vista da segurança alimentar, a presença de esporos de P. larvae no mel não representa risco direto ao consumidor humano, mas pode comprometer a qualidade do produto e sua aceitação em mercados internacionais. Países importadores frequentemente exigem certificações sanitárias que comprovem a ausência ou níveis controlados de contaminantes microbiológicos, incluindo patógenos apícolas.
Instituições de pesquisa e laboratórios de análise desempenham um papel fundamental nesse cenário, oferecendo serviços de diagnóstico, monitoramento e certificação. A análise de amostras de mel, cera, própolis e material de colmeia permite identificar focos de contaminação e orientar medidas de controle, como substituição de quadros, desinfecção de equipamentos e manejo adequado das colmeias.
Um exemplo relevante é o uso de programas de vigilância ativa em países europeus, onde amostras de mel são coletadas periodicamente e analisadas por métodos moleculares para detecção de P. larvae. Esses programas têm demonstrado eficácia na redução da incidência de AFB e na manutenção da sanidade dos apiários.
Além disso, a detecção de P. larvae é essencial em estudos epidemiológicos que buscam compreender a dinâmica de disseminação da doença, identificar fatores de risco e avaliar a eficácia de intervenções sanitárias. A integração de dados laboratoriais com informações de campo permite a construção de modelos preditivos e estratégias de controle mais eficientes.
Metodologias de Análise
A detecção laboratorial de Paenibacillus larvae envolve uma combinação de métodos microbiológicos, moleculares e imunológicos, cada um com características específicas de sensibilidade, especificidade, tempo de resposta e custo.
Cultura microbiológica
A cultura em meio seletivo continua sendo uma abordagem clássica. Meios como MYPGP (Mueller-Hinton Yeast Extract Glucose Pyruvate) são utilizados para o isolamento da bactéria a partir de amostras apícolas. Embora seja um método relativamente simples e de baixo custo, apresenta limitações importantes, como o crescimento lento e a possibilidade de contaminação por outros microrganismos.
PCR convencional e em tempo real (qPCR)
A reação em cadeia da polimerase (PCR) revolucionou a detecção de P. larvae, permitindo a identificação de material genético específico com alta sensibilidade. A qPCR, em particular, possibilita a quantificação da carga bacteriana, sendo amplamente utilizada em laboratórios de referência.
Protocolos baseados em genes como 16S rRNA e plc (fosfolipase C) são comuns, com validação em estudos publicados em revistas como Journal of Invertebrate Pathology e Applied and Environmental Microbiology. A qPCR também é recomendada por organismos internacionais para programas de vigilância.
Técnicas imunológicas
Ensaios imunoenzimáticos (ELISA) têm sido explorados para detecção de antígenos de P. larvae. Embora menos sensíveis que a PCR, esses métodos oferecem rapidez e facilidade de execução, sendo úteis em triagens iniciais.
Métodos avançados
Tecnologias emergentes incluem PCR digital (dPCR), sequenciamento de nova geração (NGS) e biossensores baseados em nanotecnologia. Esses métodos oferecem alta precisão e potencial para análise multiplex, mas ainda enfrentam desafios relacionados a custo e padronização.
Normas e protocolos
Embora não exista um único protocolo universal, muitos laboratórios seguem diretrizes adaptadas de organizações como ISO 7218 (microbiologia de alimentos) e AOAC Official Methods. A validação interna dos métodos, incluindo testes de repetibilidade, reprodutibilidade e limites de detecção, é essencial para garantir a confiabilidade dos resultados.
Considerações Finais e Perspectivas Futuras
A detecção de Paenibacillus larvae representa um componente estratégico na gestão da sanidade apícola, exigindo métodos laboratoriais robustos, sensíveis e alinhados às demandas regulatórias e produtivas. A evolução das técnicas analíticas, especialmente no campo da biologia molecular, tem ampliado significativamente a capacidade de diagnóstico precoce e monitoramento da Loque Americana.
No entanto, desafios persistem. A padronização de métodos, a redução de custos e a capacitação técnica de laboratórios são fatores críticos para a ampliação do acesso a diagnósticos de qualidade. Além disso, a integração de tecnologias emergentes, como biossensores portáteis e inteligência artificial para análise de dados, pode transformar o cenário nos próximos anos.
Do ponto de vista institucional, recomenda-se o fortalecimento de programas de vigilância, a adoção de boas práticas laboratoriais e a colaboração entre centros de pesquisa, órgãos reguladores e setor produtivo. Investimentos em pesquisa aplicada e inovação tecnológica serão fundamentais para enfrentar os desafios sanitários da apicultura contemporânea.
Em síntese, a detecção eficiente de P. larvae não é apenas uma questão técnica, mas um elemento-chave para a sustentabilidade da cadeia apícola, a segurança dos alimentos e a preservação dos ecossistemas. O avanço contínuo nessa área dependerá da convergência entre ciência, tecnologia e políticas públicas bem estruturadas.
A Importância de Escolher a Polaris Análises
Com anos de experiência no mercado, a Polaris Análises possui um histórico comprovado de sucesso em análises laboratoriais.
Empresas do setor alimentício, indústrias farmacêuticas, laboratórios e outros segmentos confiam na Polaris Análises para garantir a segurança e qualidade da água utilizada em suas atividades.
Evitar riscos de contaminação é um compromisso com a saúde de seus clientes e com a longevidade do seu negócio. Investir em análises periódicas é um diferencial que fortalece sua reputação e evita prejuízos futuros.
Para saber mais sobre os serviços da Polaris Análises - Análises de Ar, Água, Alimentos, Swab e Efluentes ligue para (11) 91776-7012 (WhatsApp) ou clique aqui e solicite seu orçamento.
❓ FAQs – Perguntas Frequentes
1. O que é Paenibacillus larvae e por que sua detecção é importante?
Paenibacillus larvae é uma bactéria formadora de esporos responsável pela Loque Americana, uma das doenças mais graves que afetam colmeias de abelhas. Sua detecção é essencial para prevenir a disseminação da doença, proteger a produção apícola e garantir a qualidade sanitária de produtos como mel, cera e própolis.
2. A presença de P. larvae no mel representa risco à saúde humana?
Não há evidências de risco direto à saúde humana associado à ingestão de mel contaminado com esporos de P. larvae. No entanto, sua presença compromete a qualidade do produto e pode representar risco sanitário para outras colmeias, além de impactar a comercialização em mercados regulados.
3. Como Paenibacillus larvae é identificado em laboratório?
A identificação pode ser realizada por métodos microbiológicos (cultura em meios seletivos), técnicas moleculares como PCR e qPCR, e, em alguns casos, por métodos imunológicos. A escolha da técnica depende da finalidade da análise, do nível de sensibilidade necessário e da infraestrutura laboratorial disponível.
4. Qual é a principal vantagem das técnicas moleculares na detecção desse patógeno?
As técnicas moleculares, como a PCR em tempo real, oferecem alta sensibilidade e especificidade, permitindo detectar pequenas quantidades de material genético de P. larvae, inclusive antes do aparecimento de sinais clínicos nas colmeias.
5. A análise laboratorial pode detectar a doença antes dos sintomas nas colmeias?
Sim. Métodos avançados, especialmente os moleculares, permitem identificar a presença do patógeno em estágios iniciais, possibilitando intervenções preventivas e reduzindo o risco de disseminação da Loque Americana.
6. A detecção laboratorial contribui para o controle da Loque Americana?
Sim. Programas de monitoramento baseados em análises laboratoriais permitem identificar focos de contaminação, orientar medidas de manejo sanitário e evitar a propagação da doença, sendo fundamentais para a sustentabilidade da atividade apícola.
_edited.png)



Comentários